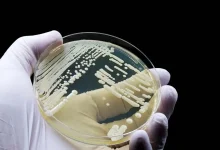
کشف عفونت قارچی جدید در چین؛ آیا گرمایش جهانی مقصر است؟

یوبیسافت میخ بر تابوت بازی Watch Dogs میکوبد؟

یوبیسافت میخ بر تابوت بازی Watch Dogs میکوبد؟
بازی Watch Dogs: Legion در سال ۲۰۲۰ شکست گستردهای برای مجموعهی جهانباز یوبیسافت به بار آورد و اکنون با گذشت چهار سال، سؤالها دربارهی آیندهی بازی یادشده بیشتر میشود؛ اما بهنظر میرسد آیندهای برای این بازی وجود ندارد.
جاناتان (j0nathan)، افشاگر، میگوید بازی Watch Dogs «مرده و دفن شده است.» این افشاگر در پاسخ به پرسشی در مورد آیندهی بازی و اینکه آیا قسمت جدیدی ساخته میشود یا خیر، پاسخ داد که خبری از واچ داگز جدید نخواهد بود.
ظاهراً پس از شکست تجاری Watch Dogs: Legion، یوبیسافت تعدادی از پروژههای Watch Dogs را که قبلاً برنامهریزی شده بودند، از جمله یک بازی بتل رویال، لغو کرده است.
اکنون باید دید که آیا یوبیسافت در آینده قصد توسعهی بازی جدید Watch Dogs را دارد یا خیر؛ اما بهنظر میرسد که این مجموعه دیگر برای شرکت اولویت ندارد.
درحالیکه بازی جدید Watch Dogs ممکن است به این زودی عرضه نشود؛ ماه گذشته اعلام شد که فیلمی سینمایی براساس این بازی در دست ساخت قرار دارد.
منبع : زومیت
مجله خبری lastech